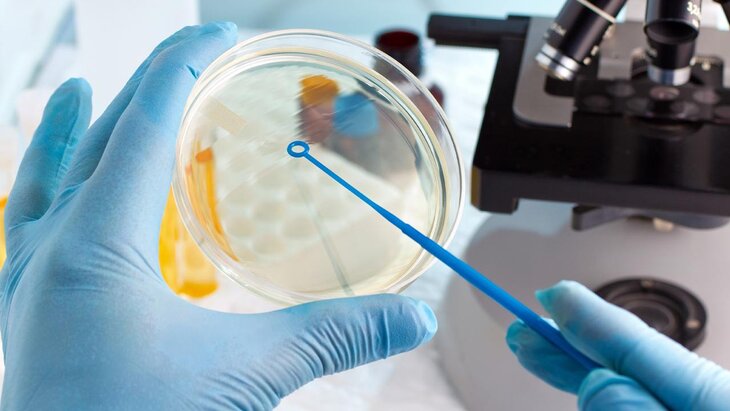

Фото: depositphotos/angellodeco
В Китае врачи зафиксировали несколько случаев заражения разновидностью вируса оспы обезьян lb. Возможность для распространения заболевания уже купирована, передает ТАСС со ссылкой на Китайский центр по контролю и профилактике заболеваний.
По данным центра, источником заражения стал иностранец, который прибыл в страну из Демократической Республики Конго. После выявления болезни профильные ведомства в городах Пекин и Тяньцзинь, а также провинциях Чжэцзян и Гуандун запустили совместный механизм профилактики и контроля распространения заболевания.
Также оспой заразились четыре человека, которые тесно контактировали с инфицированным. Они испытывали легкие симптомы, в частности сыпь и герпес. Сейчас заболевшие находятся под наблюдением врачей.
Первый случай заражения оспой обезьян выявили в ноябре 2024 года в центральной канадской провинции Манитоба. Этот случай связан с поездками и вспышкой вируса в Центральной и Восточной Африке. Пациента обследовали и отправили домой.
В Роспотребнадзоре исключили риски распространения разновидности оспы обезьян lb в России. Как пояснили в ведомстве, клада Ib была впервые обнаружена в Демократической Республике Конго (ДРК) и зарегистрирована в апреле прошлого года. Данной кладой преимущественно затронуты восточные районы ДРК и соседние страны.
В свою очередь, в ВОЗ назвали тревожной эпидемиологическую ситуацию с оспой обезьян в Африке. Так, в период с 1 января 2022 года по 30 ноября 2024 года в 127 странах зарегистрировали в общей сложности 117 663 случая заболевания оспой обезьян и 263 случая смерти.
Сотрудники Роспотребнадзора отслеживают вспышки вирусных инфекций по всему миру